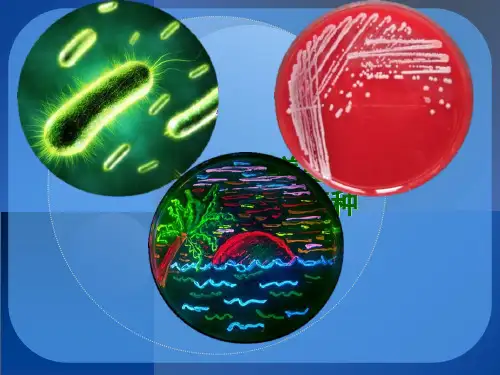

(E.c1/02/01
2
一、形态及染色特性
革兰氏阴性小杆菌,散在或成对,周毛菌,有菌毛。
2021/02/01
3
二、培养特性
1.普通培养基上生长良好,光滑、 湿润、半透明、灰白色菌落;
2. 麦康凯琼脂上形成红色菌落, 伊红美蓝琼脂上产生黑色带金属 光泽菌落;
3.致病菌株在绵羊血平板上呈β 型溶血;
2021/02/01
三糖铁培养基
15
三、抗原及血清型
(一)抗原
1 .菌体抗原(O抗原):其成分为LPS的多糖侧链。58种,耐
热,1个菌株可含多种,以阿拉伯数字表示。
2. 荚膜抗原(K抗原):与毒力有关,又称Vi抗原。有的菌株有,
有的菌株无。
3.鞭毛抗原(H抗原):其成分为蛋白质,不耐热,63种,
分为两相: (1)第1相(特异相):小写英文字母表示 (2)第2相(非特异相):阿拉伯数字表示
(一)产肠毒素大肠杆菌(ETEC)
引起人和动物腹泻,主要毒力因子有两类:
1. 黏附素(定居因子):菌毛,能黏附宿主的小肠上皮
细胞,虽不是直接的致病因子,却是首要的毒力因子。
2. 肠毒素:分泌到胞外的一种蛋白质性毒素。
3. (1)不耐热肠毒素(heat-labile enterotoxin,LT)
4.
对热敏感,可转变成类毒素,具有A和B亚单位。
5. (2)耐热肠毒素(heat-stable enterotoxin,ST)
6.
耐热,分子量小,无免疫原性。
2021/02/01
9
(二)产类志贺毒素大肠杆菌(SLTEC)
引起猪水肿病,有两类毒力因子: 1. 黏附性菌毛 2. F18,有助于细菌在肠黏膜上皮细胞定居和繁